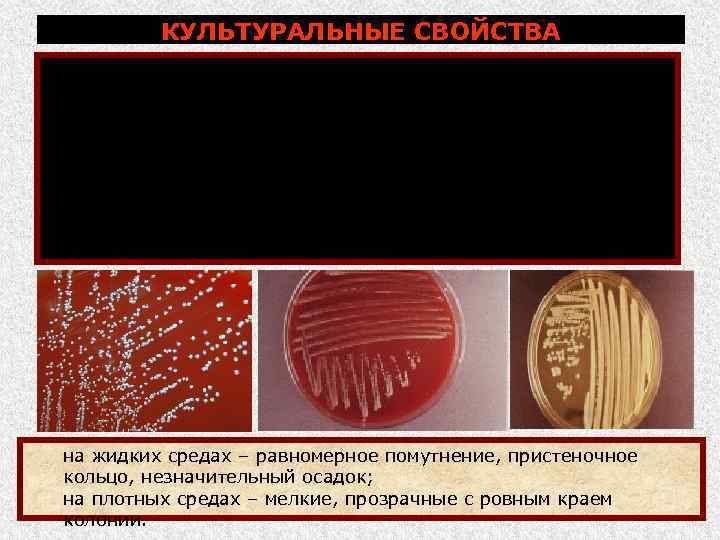
КУЛЬТУРАЛЬНЫЕ СВОЙСТВА Растут на различных питательных средах, лучше на печеночных средах с добавлением глюкозы,

Est modus in rebus Все имеет свою цену

Бруцеллез Кашко Леонид Степанович кандидат ветеринарных наук, доцент

БРУЦЕЛЛЕ 3 (лат. , англ. - Brucellosis; мальтийская лихорадка, болезнь Банга, эпизоотический аборт) Бруцеллез - хроническая болезнь животных многих видов, проявляющаяся у самок, в основном, абортами, задержанием последа, а у самцов – орхитами и эпидидимитами Болеет человек.

Историческая справка, распространение, экономический ущерб 1861 г. – Мэрстон впервые описал бруцеллез при заболевании солдат английского гарнизона на о. Мальта; 1887 г. Д. Брюс впервые обнаружил возбудителя и выделил чистую культуру (в его честь возбудитель назван бруцеллой, а заболевание бруцеллез); 1896 г. Б. Банг и В. Стрибольт выделили возбудителя бруцеллеза крупного рогатого скота; 1897 г. – А. Райт и Д. Семпл – предложили для диагностики бруцеллеза РА; 1909 г. Ф. Гутира выделил возбудителя бруцеллеза у овец.

Историческая справка, распространение, экономический ущерб Распространение. Болезнь распространена во многих странах Азии, Африки, Центральной и Южной Америки. Болезнь регистрируется в РФ, особенно в ЮФО. Экономический ущерб складывается из недополучения приплода, убоя неблагополучного поголовья и затрат на проведение ПЭМ.

Бруцеллез 2011 г. – зарегистрировано (н/п): КРС МРС 277 36 351 случай первичного бруцеллеза у людей!

Регионы, неблагополучные по бруцеллезу КРС Регион К во н/п / больных Алтайский кр 5/124 Р. Ингушетия 9/166 Астраханская обл 69/1095 Р. Кабардино Балкария 0/715 Забайкальский кр 2/108 Р. Карачаево Черкесия 0/1467 Р. Дагестан 7/359 Р. Северная Осетия 0/628 Р. Калмыкия 5/218 Ростовская обл 17/858 Р. Чечня 0/810 Тверская обл 1/5 Саратовская обл 4/153 Ставропольский кр 70/736 Волгоградская обл 4/207 Воронежская обл 0/488

Регионы, неблагополучные по бруцеллезу МРС Регион К во н/п / больных Р. Калмыкия 6/569 Р. Дагестан 4/524 Саратовская обл 1/236 Тверская обл 0/7 Брянская обл 2/144 Калужская обл 1/1 Московская обл 2/16 Смоленская обл 6/19 Регион К во н/п / больных

Этиология Classification Kingdom: Bacteria Division Gracilicutes Family: Brucellaceae Genus: Brucella Species: 6 видов бруцелл Gr , мелкие коккобактерии (0, 3 0, 6 мкм ) или мелкие палочки (0, 6 2, 5 мкм), располагаются одиночно, парами и небольшими группами, не подвижны. Спор не образует (некоторые штаммы имеют капсулу).

Этиология род Brucella включает 6 видов, некоторые имеют несколько биоваров: Вид бруцелл Число биоваров Восприимчивые животные B. abortus 9 Крупный рогатый скот B. melitensis 3 Овцы и козы B. suis 5 Свиньи B. neotome Пустынные кустарниковые крысы B. ovis Бараны (инфекционный эпидидимит) B. canis Собаки

Этиология Лабораторные животные морские свинки, в меньшей степени белые мыши Антигенная структура соматические антигены: М и А (соотношение у разных видов различное). Антигены активно индуцируют синтез антител, выявляемых в РП, РА, РСК и др.
КУЛЬТУРАЛЬНЫЕ СВОЙСТВА Растут на различных питательных средах, лучше на печеночных средах с добавлением глюкозы, сыворотки или глицерина: (МППБ), (МППГГА), (МГГБ и МГГА) с 10% ной глюкозой и 2 3% ным глицерином. особенности выделения возбудителя: строгие аэробы; оптимальная температура 37 С; срок культивирования от 15 до 30 дн. на жидких средах – равномерное помутнение, пристеночное кольцо, незначительный осадок; на плотных средах – мелкие, прозрачные с ровным краем колонии.

Этиология Сохранение возбудителя во внешней среде (отн. устойчив) в воде, почве более 5 месяцев в навозе до 120 дней Т+80. . . +85 С через 5 мин Сохранение возбудителя в продукции животноводства в охлажденном молоке 6 8 дней в замороженном мясе 320 дней в масле, сырах 40 60 дней Инактиванты/дезинфектанты: I группа (не устойчивые) гидроксид натрия (%) 2 Гипохлорит (%) 2

Эпизоотология Видовая и возрастная восприимчивост ь Источники резервуары возбудителя инфекции Все виды домашних и многие виды диких животных, особенно КРС, МРС, свиньи. Взрослые половозрелые животные более восприимчивы, чем молодые и больные и микробоносители, выделяющие возбудителя с околоплодными водами, плодными оболочками, абортированными плодами, выделениями из половых органов Способ заражения и механизм передачи возбудителя горизонтальный – алиментарным и контактным (половым) путями через слизистые оболочки и кожу. Факторы передачи: корма, вода, кормушки, предметы ухода, одежда обслуживающего персонала, контаминированные возбудителем

Эпизоотология Интенсивность проявления ЭП У КРС и МРС в виде эпизоотии, у других видов спорадически Сезонность проявления болезни, периодичность не характерны Факторы, способству неудовлетворительные условия содержания и кормления ющие возникновеживотных нию и распространению болезни Заболеваемость, летальность заболеваемость: при первичном заносе до 60 % летальность 1 2 %

Патогенез В ИП различают три фазы: I фаза (первичная, регионарная): соответствует ИП болезни бруцеллы проникают в организм и задерживаются в регионарных лимфатических узлах, где уничтожаются или размножаются и проникают в кровь и заносятся в паренхиматозные органы. II фаза (генерализации)– у беременных животных вызывают воспалительно некротические изменения плодных оболочек, приводящими к абортам, рождению слабого и нежизнеспособного приплода, задержанию последа, эндометритам (эритриол фактор роста для бруцелл). III фаза (вторичной локализации): латентное течение бактерионосительство и аллергическая перестройка организма. В патогенезе определенное значение имеют L формы бруцелл (длительная персистенция).

Клиника ИП 2 4 недели и более. Течение в основном, в латентное (у не беременных животных). Выявляют серологическими или аллергическими методами.

Клиника У беременных животных аборты во второй половине беременности: у коров чаще на 8 м мес. ; у овец и коз на 3 5 мес. ; у свиноматок как в первой, так и во второй половине супоросности. У КРС и МРС повторные аборты редко, у свиней могут быть многократными.

Клиника задержание последа; гнойный эндометрит. воспаление яичников и фаллопиевых труб; нарушение полового цикла и временное или стойкое бесплодие.

Клиника У самцов: орхиты и эпидидимиты; увеличение семенников и опухание мошонки

Бруцеллез свиней

Клиника бурситы, гигромы, артриты, тендовагиниты

Клиника У лошадей бурситы в области затылка и холки с некрозом хрящей, остистых отростков, образованием свищей.

Инфекционный эпидидимит баранов

Патологоанатомические изменения Не характерны. У абортировавших животных плодные оболочки набухшие, покрыты хлопьями фибрина и гноя. У абортировавших плодов – отеки подкожной клетчатки, гастроэнтерит, пневмония, некротические участки в печени.

Патологоанатомические изменения n у самцов – гнойно-некротические орхиты

Диагностика и дифференциальная диагностика Диагностика комплексная с учетом эпизоотологических данных, клинических признаков, результатов серологического, аллергического и бактериологического исследований.

Схема лабораторной диагностики бруцеллеза Сыворотка крови, молоко Патологический материал (аборт-плоды) Серологические исследования (РА, РСК, РДСК, РНГА, РИД, РБП, РК с молоком) Посев на питательные среды (МППБ и др. ) Микроскопия: окраска по Граму, Козловскому Биопроба на морских свинках Выделение чистой культуры и ее идентификация Морфология, Гр- Результат биопробы РА на стекле Культуральные свойства

Серологическая диагностика Серологический метод основной метод прижизненной диагностики бруцеллеза. РА положительная при наличии агглютинации с сыворотками крови крупного рогатого скота и лошадей в разведении 1 : 200 (200 ME); овец, коз 1: 100 (100 ME) с оценкой не менее чем на два креста. РА сомнительная при наличии агглютинации в разведении 1: 50 (50 ME) с сыворотками крови крупного рогатого скота и лошадей; 1: 25 (25 ME) с сыворотками овец, коз с оценкой не менее чем на два креста.

Серологическая диагностика РСК специфичный и высокочувствительный метод. Показания РСК более постоянны и сохраняются дольше: реакция позволяет выявить большее количество больных с давней инфекцией. РДСК более чувствительный тест, чем РСК. При инфекционном эпидидимите баранов используют только РДСК с овисным антигеном. РСК и РДСК считают положительными при задержке гемолиза на 2 4 креста в одном или двух разведениях (1: 5 или 1: 10)

Серологическая диагностика РБП исследуют сыворотки КРС, МРС, лошадей, свиней. Реакцию проводят с бруцеллезным антигеном, окрашенным бенгальским розовым, на пластинках с лунками. При положительной реакции в течение 4 мин появляются мелкие или крупные хлопья агглютината розового цвета.

Серологическая диагностика бруцеллеза РИД – используют для выявления антител в сыворотках крови больных и зараженных животных (КРС, МРС) (дифференциальная реакция)

Серологическая диагностика бруцеллеза РНГА для выявления антител в сыворотках крови больных и зараженных животных (КРС) Схема РНГА: эритроциты (1), нагруженные антигеном (3), связываются специфическими антителами (4).

Серологическая диагностика КР с молоком - ставят с цельным свежим или консервированным формалином молоком коров и антигеном взвесью убитых бруцелл, окрашенных в синий цвет гематоксилином. При наличии в молоке специфических антител происходит агрегация антигена, образовавшийся комплекс адсорбируется сливками молока и поднимается с ними вверх, образуя четкое, окрашенное кольцо. Результаты учитывают визуально и оценивают в крестах: +++ четко выраженное синее кольцо в верхней части молока, остальная часть молока белая; ++ достаточно выраженное синее кольцо, столбик молока синеватого цвета. Пробы, давшие реакцию с оценкой три и два креста, считают положительными. КР с молоком используется на рынках.

Аллергическая диагностика Для аллергической диагностики используют бруцеллин ВИЭВ, изготовляемый из неагглютиногенного и авирулентного штамма В. abortus B 1. У овец и коз пальцебральная проба, у свиней внутрикожно с наружной стороны ушной раковины. У больных животных на месте введения бруцеллина развивается воспалительная реакция

Диагностика Диагноз на бруцеллез считается установленным : при выделении культуры бруцелл из биоматериала или положительной биопробе; при положительных результатах серологических исследований не вакцинированных животных при следующих показателях: для КРС и лошадей – РА с наличием антител 200 МЕ/мли выше; для овец и коз РА 100 МЕ/мл и выше; для собак РА 50 МЕ/мл и выше; для всех видов животных РСК в разведении сыворотки 1: 5 и выше; для КРС – кроме того положительной РИД. При выявлении в стадах крупного рогатого скота положительно реагирующих животных только в РА не выше 200 МЕ/мл и РСК в разведении сыворотки крови не выше 1: 5 проводят повторное исследование через 15 30 дней в РА, РСК. При повышении титров в Р А или РСК заболевании е считается установленным.

Дифференциальная диагностика: кампилобактериоз, хламидиоз, инфекционный эпидидимит, лептоспироз, листериоз, сальмонеллез, незаразные болезни с симптомами аборта.

Лечение не проводят. Больные животные подлежат убою.

Иммунитет при бруцеллезе относительно напряженный и формируется медленно. Иммунитет при бруцеллезе клеточный и обеспечивается Т системой лимфоцитов. Наличие антител в сыворотках крови животных не предохраняет их от повторного заражения. Инфекционный иммунитет переходит в постинфекционный постепенно и сопровождается освобождением организма от возбудителя, в результате чего может наступить самовыздоровление. Для бруцеллеза характерно развитие гиперчувствительности замедленного типа (аллергия).

Специфическая профилактика Для специфической профилактики бруцеллеза предложены вакцины: живая вакцина из штамма 19 В. abortus. Этот штамм выделил в 1923 г. Бук, в процессе десятилетнего пассирования культуры на картофельном агаре, т. е. был селекционирован иммуногенный мутант. Вакцинация профилактирует аборты и распространение бруцеллеза в стаде, однако сопровождается длительной серопозитивностью привитых животных. сухая живая вакцина из слабоагглютиногенного штамма 82 В. abortus против бруцеллеза крупного рогатого скота; живая вакцина из штамма Рев 1 бруцелл вида мелитензис против бруцеллеза мелкого рогатого скота; инактивированная адьювант вакцина из штамма В. abortus KB 17/100, которая создает напряженный иммунитет у крупного рогатого скота, не обладает реактогенными и абортогенными свойствами, не

Меры профилактики Общие меры соблюдение владельцами животных ветеринарно санитарных правил содержания и эксплуатации животных. Специальные профилактические меры обязательные серологические исследования быков производителей, коров, нетелей и телок старше 1 года на бруцеллез один раз в год.

Меры борьбы При установлении диагноза на бруцеллез хозяйство (ферма) объявляют неблагoполучным и вводят ограничения. По условиям ограничений запрещается: ввоз на неблагополучные фермы, вывоз из них восприимчивых к бруцеллезу животных (кроме сдачи на убой); перегруппировка животных внутри хозяйства без разрешения главного ветеринарного врача; заготовка на неблагополучных территориях племенных и пользовательных животных, грубых кормов для вывоза их в другие хозяйства и районы, а также проведение ярмарок, базаров и выставок животных; использование больных (положительно реагирующих) бруцеллезом животных и полученного от них приплода для воспроизводства стада; вывоз необеззараженного молока с неблагополучной фермы на молокоперерабатывающее предприятие.

Меры борьбы Молоко от коров, положительно реагирующих на бруцеллез, обеззараживают кипячением или переработкой на масло топленое – сырец (также как и от коров, положительно реагирующих на бруцеллез, в благополучных хозяйствах до установления (исключения) диагноза). Молоко (сливки) от не реагирующих коров неблагополучного стада обеззараживают при температуре +70 С в течение 30 мин или при температуре +85. . . +90 С в течение 20 с или кипячением. Оздоровление крупного рогатого скота от бруцеллеза в благополучных регионах осуществляется путем полной ликвидации поголовья неблагополучного хозяйства (фермы) и проведения санации помещений. лимфаденит

Меры борьбы Дезинфекция, дезинсекция, дератизация, санитарный ремонт животноводческих помещений и другие ветеринарно санитарные мероприятия. Хозяйство признается оздоровленным от бруцеллеза крупного рогатого скота и с него снимается ограничения: после убоя неблагополучного поголовья, санации животноводческих помещений, территории ферм и получения двух отрицательных результатов серологических исследований на бруцеллез с интервалом 30 дней животных, имевших контакт с животными неблагополучного стада, включая скот, принадлежащий гражданам.

Меры по охране людей от заражения бруцеллезом Заражение человека бруцеллезом: контактный путь – больные животные, инфицированные сырье и продукты (фермы, мясокомбинаты и т. д. ); алиментарный путь – при употреблении продуктов, полученных от больных животных.
